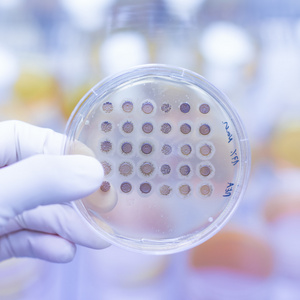
琼脂琼脂平板上生长的真菌照片
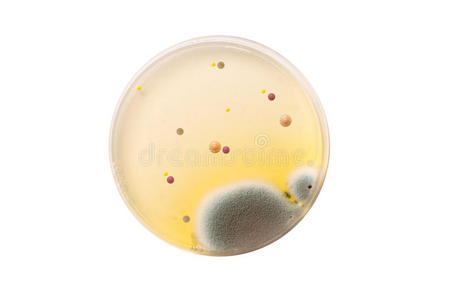
微生物菌类平板医学研究用培养皿微生物学白色琼脂平板上的细菌和真菌
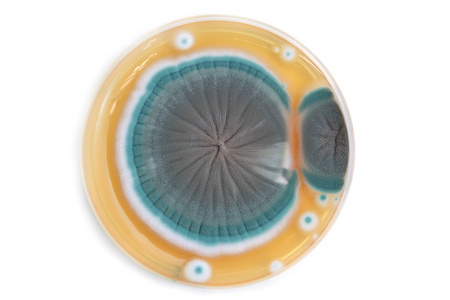
真菌菌落真菌对琼脂平板上的菌落照片

真菌平板

显色平板~ 真菌787878
图片尺寸1080x1439
发现一个平板长了好看的霉菌,闲来无事就在显微镜下观察了一下菌落
图片尺寸640x1138
请大神们帮忙看一下平板菌的生长情况
图片尺寸507x900
请虫友帮我看看真菌在平板上长这个样子是不是污染了.
图片尺寸675x900
显色平板~ 真菌787878
图片尺寸1080x1439
殖民地的微生物真菌微生物平板照片
图片尺寸450x300
血平板真菌形态
图片尺寸1080x1439
求助用平板培养的真菌的图片
图片尺寸600x450
图8患者脓液标本接种于血平板35℃培养48小时,可见大量白色菌落,菌落
图片尺寸463x525
像这种平板里有很多小的菌落也要数吗?
图片尺寸501x500
念珠菌显色平板上的不同真菌#真菌 - 抖音
图片尺寸1440x1920
求助用平板培养的真菌的图片
图片尺寸600x450
琼脂琼脂平板上生长的真菌照片
图片尺寸300x300
微生物菌类平板医学研究用培养皿微生物学白色琼脂平板上的细菌和真菌
图片尺寸452x300
真菌菌落真菌对琼脂平板上的菌落照片
图片尺寸450x300
求助用平板培养的真菌的图片
图片尺寸600x450
观察培养微生物系列活动——2探究不同环境中的细菌真菌
图片尺寸2000x2667
生长的真菌菌落的菌丝生长被转移到新鲜的pda平板和pda斜线上,以获得
图片尺寸640x580
图 1 2株内生拮抗细菌对病原菌平板对抗 a: pn1; b: pn
图片尺寸1575x809
白底琼脂平板上的真菌
图片尺寸1200x795